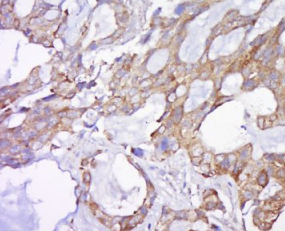

英文名称:Anti-Bak
中文名称:Bcl-2同源拮抗剂抗体(Bak)
抗体来源:兔子
克隆类型:多克隆
交叉反应:人、小鼠、大鼠
产品应用:WB=1:500-2000 ELISA=1:500-1000 IHC-P=1:100-500 IHC-F=1:100-500 Flow-Cyt=1μg/Test IF=1:100-500(石蜡切片需做抗原修复)
分 子 量:23kDa
细胞定位:细胞浆 细胞膜
状态:冻干或液体
浓度:1mg/ml
来源于:KLH conjugated synthetic peptide derived from mouse Bak:21-120/209
亚型:IgG
纯化方法:affinity purified by Protein A
储存液:0.01M TBS(pH7.4) with 1% BSA, 0.03% Proclin300 and 50% Glycerol.
别 名:Apoptosis Regulator Bak; BAK 1; BAK; BAK like; Bak NT; BAK1; Bcl 2 homologous antagonist/killer; Bcl 2 like 7 protein; Bcl2 homologous antagonist killer; Bcl2 like 7 Protein; BCL2-antagonist/killer 1; BCL2L7; CDN 1; CDN1; Cell death inhibitor 1; MGC117255; MGC3887; NBak; Pro apoptotic protein BAK; BAK_HUMAN; BAK_MOUSE.
保存条件:在-20°C下保存一年。避免反复冻融。冻干抗体在室温下至少稳定一个月,并在-20°C下保持一年以上。当在无菌pH7.4 0.01M PBS或抗体稀释剂中重组时,抗体在2-4°C下至少稳定两周。
产品介绍:
该基因编码的蛋白属于bcl2蛋白家族。bcl2家族成员形成寡聚体或异二聚体,并充当参与多种细胞活动的抗或促凋亡调节器。这种蛋白定位于线粒体,并能诱导细胞凋亡。与线粒体电压依赖性阴离子通道相互作用并加速其开放,从而导致膜电位的损失和细胞色素c的释放。这种蛋白也在细胞应激后与肿瘤抑制因子p53相互作用。[参考文献编号:2008年7月]
功能:
在适当的刺激下,通过结合和对抗bcl2或其腺病毒同系物E1b19k蛋白的抗凋亡作用,加速程序性细胞死亡。低水平的锌离子抑制细胞凋亡。
子单元:
属于BCL-2家族。
亚细胞位置:
线粒体膜。
组织特异性:
在多种组织中表达。
相似性:
属于BCL-2家族。
重要提示:
本产品仅用于研究用途,不用于人类、治疗或诊断应用
Bak属于bcl-2基因家族中的成员,具有抑制凋亡的作用。BAK基因是新发现的细胞凋亡促进因子,BAK含BH1和BH2结构域,其功能类似于BAX;拮抗BCL2、BCL-XL的抗凋亡效应。
组织/细胞:人肺癌;4%多聚甲醛固定石蜡包埋;
抗原提取:柠檬酸缓冲液(0.01M,pH 6),15min煮沸,用3%过氧化氢阻断内源性过氧化物酶30min;37℃下阻断缓冲液(正常山羊血清)20 min;
孵育:抗bak多克隆抗体,未结合1:500,在4°C下过夜,然后接合二级抗体和DAB染色。
公司优势:
1)质量:我司提供的的试剂为世界。
2)价格:价格实惠,量大从优。
4)服务:提供完整的售前、售后和售中服务。售后到底。
如需订购Bcl-2同源拮抗剂抗体(Bak),请联系我们。
| Anti-DFF-45/ICAD (DNA fragmentation factor-45) DNA裂解因子抗体 |
| Anti-Digoxin IgG (兔抗Dig-YTA) 兔抗抗体 |
| Anti-DISC1(disrupted in schizophrenia1)(CT) DISC1 C端抗体 |
| Anti-DISC1(disrupted in schizophrenia1)(NT) DISC1 N端抗体 |
| anti-DJ-1 丝裂原依赖性癌基因蛋白抗体 |